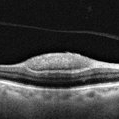

-
 Dehemoglobinized sub-internal limiting membrane hemorrhage
Dehemoglobinized sub-internal limiting membrane hemorrhage
Jul 29 2022 by JORGE SOBERANES
Fundus photograph of a 70-year-old man with Valsalva retinopathy manifested as premacular hemorrhage (sub-ILM) in dehemoglobinized process.
Photographer: Jorge I. Soberanes, Asociación para Evitar la Ceguera en México.
Imaging device: Zeiss Clarus 700
Condition/keywords: dehemoglobinized hemorrhage, sub-inner limiting membrane hemorrhage, valsalva retinopathy
-
 Sub-internal limiting membrane hemorrhage in Valsalva retinopathy
Sub-internal limiting membrane hemorrhage in Valsalva retinopathy
Jul 29 2022 by JORGE SOBERANES
A fundus photography of a 70-year-old man with premacular hemorrhage (Sub-internal limiting membrane) due to Valsalva retinopathy
Photographer: Jorge I. Soberanes, Asociación para Evitar la Ceguera en México.
Imaging device: Zeiss Clarus 700
Condition/keywords: premacular hemorrhage, sub-inner limiting membrane hemorrhage, valsalva retinopathy
-
OCT of a sub-internal limiting membrane hemorrhage in Valsalva retinopathy
OCT of a sub-internal limiting membrane hemorrhage in Valsalva retinopathy
Jul 29 2022 by JORGE SOBERANES
Optical coherence tomography of a 70-year-old man with a sub-internal limiting membrane due to Valsalva retinopathy
Photographer: Jorge I. Soberanes, Asociación para Evitar la Ceguera en México.
Imaging device: PLEX Elite 9000, Zeiss
Condition/keywords: OCT, sub-inner limiting membrane hemorrhage, swept source, valsalva retinopathy

A project from the American Society of Retina Specialists